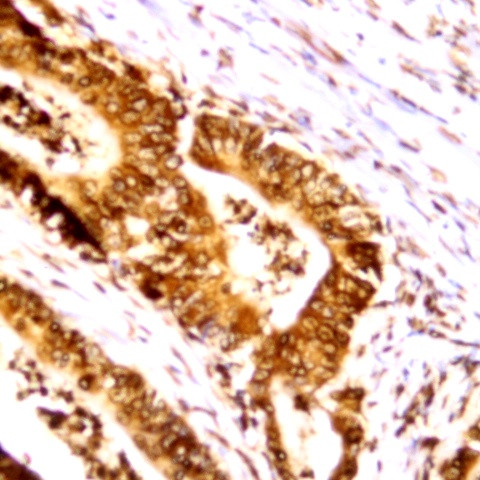
Phospho-DCLK1 (Ser30) Antibody in Immunohistochemistry (Paraffin) (IHC (P))

Search
AbboMax
Phospho-DCLK1 (Ser30) Polyclonal Antibody
{{$productOrderCtrl.translations['antibody.pdp.commerceCard.promotion.promotions']}}
{{$productOrderCtrl.translations['antibody.pdp.commerceCard.promotion.viewpromo']}}
{{$productOrderCtrl.translations['antibody.pdp.commerceCard.promotion.promocode']}}: {{promo.promoCode}} {{promo.promoTitle}} {{promo.promoDescription}}. {{$productOrderCtrl.translations['antibody.pdp.commerceCard.promotion.learnmore']}}
图: 1 / 2
Phospho-DCLK1 (Ser30) Antibody (630-620) in IHC (P)


产品信息
630-620
种属反应
宿主/亚型
分类
类型
抗原
偶联物
形式
浓度
纯化类型
保存液
内含物
保存条件
运输条件
产品详细信息
Positive control: Human brain tissue
Cellular location: Cytoplasm.
靶标信息
DCAMKL1 (DCLK1) serine/threonine kinase or DCLK1 or doublecortin-like kinase 1 contains two N-terminal doublecortin domains (which bind microtubules and regulate microtubule polymerization), a C-terminal serine/threonine protein kinase domain (which shows substantial homology to Ca2+/calmodulin-dependent protein kinase), and a serine/proline-rich domain in between the doublecortin and the protein kinase domains (which mediates multiple protein-protein interactions). DCAMKL1 is a microtubule-associated kinase that can undergo autophosphorylation. DCAMKL1 has microtubule-polymerizing activity that is independent of its protein kinase activity. DCAMKL1 is involved in several different cellular processes, including neuronal migration, retrograde transport, neuronal apoptosis and neurogenesis.
仅用于科研。不用于诊断过程。未经明确授权不得转售。
篇参考文献 (0)
生物信息学
蛋白别名: Calcium/calmodulin-dependent protein kinase type I-like CPG16; CLICK-I beta; double cortin and calcium/calmodulin-dependent protein kinase-like 1; doublecortin and calcium/calmodulin-dependent protein kinase-like 1; Doublecortin domain-containing protein 3A; Doublecortin-like and CAM kinase-like 1; Doublecortin-like kinase 1; RP11-113P14.1; Serine/threonine-protein kinase DCLK1
基因别名: 1700113D08Rik; 2810480F11Rik; AI836758; Ania4; CL1; Click-I; CLICK1; Cpg16; DCAMKL1; DCDC3A; Dcl; DCLK; DCLK1; KIAA0369; mKIAA0369
UniProt ID: (Human) O15075, (Mouse) Q9JLM8, (Rat) O08875
Entrez Gene ID: (Human) 9201, (Bovine) 613449, (Mouse) 13175, (Rat) 83825